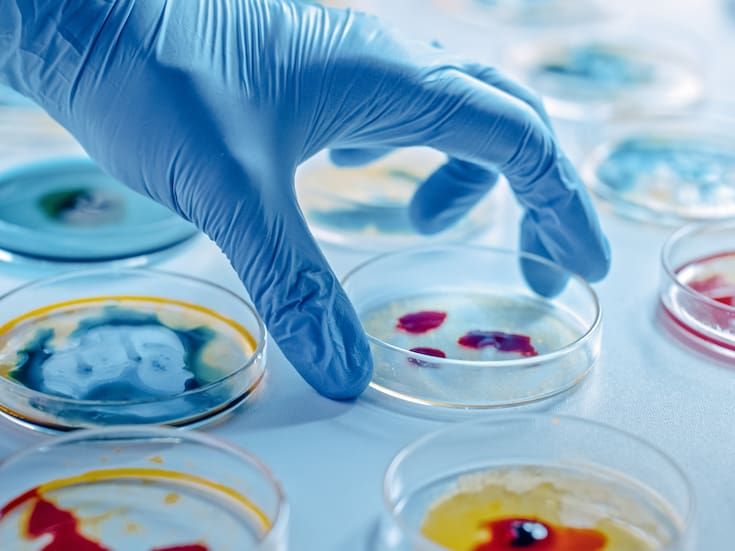

Primaria Migdelina Gil Samaniego elige a su sociedad de alumnos con sistema de urnas electrónicas y apoyo del IEE
Participaron 222 estudiantes de 6 a 11 años

La primaria Migdelina Gil Samaniego ubicada en la colonia Balderrama, celebró las elecciones de planilla con un sistema de urnas electrónicas, con el apoyo del Instituto Estatal Electoral y de Participación Ciudadana (IEE)
Miguel Navarro Bustamante, director del plantel, comentó que tuvieron una participación de 222 alumnos de la escuela primaria ubicada en la avenida José Carmelo y Guadalupe Victoria.
Indicó que se postularon dos planillas, blanca y negro, para encabezar la próxima Sociedad de Alumnos que la conforma un presidente, secretario, tesorero y seis vocales.
Que los niños vivan el valor de la democracia y en la renovación de la sociedad de alumnos año con año, se hace un ejercicio de que los niños participen, se viva el proceso electoral con el árbitro que es el Instituto Estatal Electoral.
Mencionó.

Hasta ayer la contienda iba reñida, los estudiantes de 6 a 11 años de edad, hicieron filas para emitir su voto de manera digital, en urnas electrónicas que aportó el IEE además que orientó en su vigilancia.
Los niños andan motivados, pues hubo contienda y la idea es que se vivan los valores la participación, el respeto entre una planilla y otra, y eso es una algarabía, la verdad, contentos los niños, contentas la familias y de eso se trata.
Declaró Navarro Bustamante.

A los niños que emitieron su sufragio se les aplicó una tinta indeleble en la huella del dedo pulgar, como signo de su participación, además que otros menores formaron parte del consejo de vigilancia para que no se repitiera el voto.
Será el próximo lunes cuando se den a conocer los resultados que permanecen en un sobre negro, durante los honores a la bandera en presencia de las autoridades electorales.
Elección en primaria Migdelina Gil Samaniego para sociedad de alumnos.

Niños que encabezaron las elecciones.
- Planilla blanca.
Candidato para presidente: David Gael Haro Díaz, 11 años de edad, alumno de sexto grado B.
- Planilla negra.
Candidato para presidente: Lucas Said Márquez de la Cruz, de 10 años de edad, alumno de quinto A.
Fuente: director del plantel, Miguel Navarro Bustamante.
Te podría interesar: Hermosillo se prepara para el Festival del Globo 2025: disfruta vuelos libres, show de drones y concierto de Piso 21
Sigue nuestro canal de WhatsApp
Recibe las noticias más importantes del día. Da click aquí

Grupo Healy © Copyright Impresora y Editorial S.A. de C.V. Todos los derechos reservados